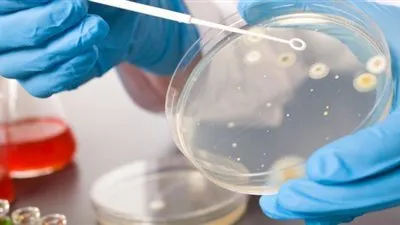
علم الأحياء الدقيقة الطبي: استكشاف عوالم الكائنات الصغيرة بأهميتها الطبية

عاجل
اسعار المكرونه اليوم الأربعاء 21 يناير 2026 فى المنيا
مواقيت الصلاه اليوم الأربعاء 21 يناير 2026 فى محافظه المنيا
البيت الأبيض: خطاب ترامب في دافوس سيركز على مبدأ أمريكا أولا
اسعار الفراخ البيضا والساسو اليوم الأربعاء 21 يناير 2026 فى المنيا
بحضور محافظ الدقهلية وبرعاية وزارة الشباب والرياضة.. ختام ناجح لتصفيات دوري مراكز شباب مصر